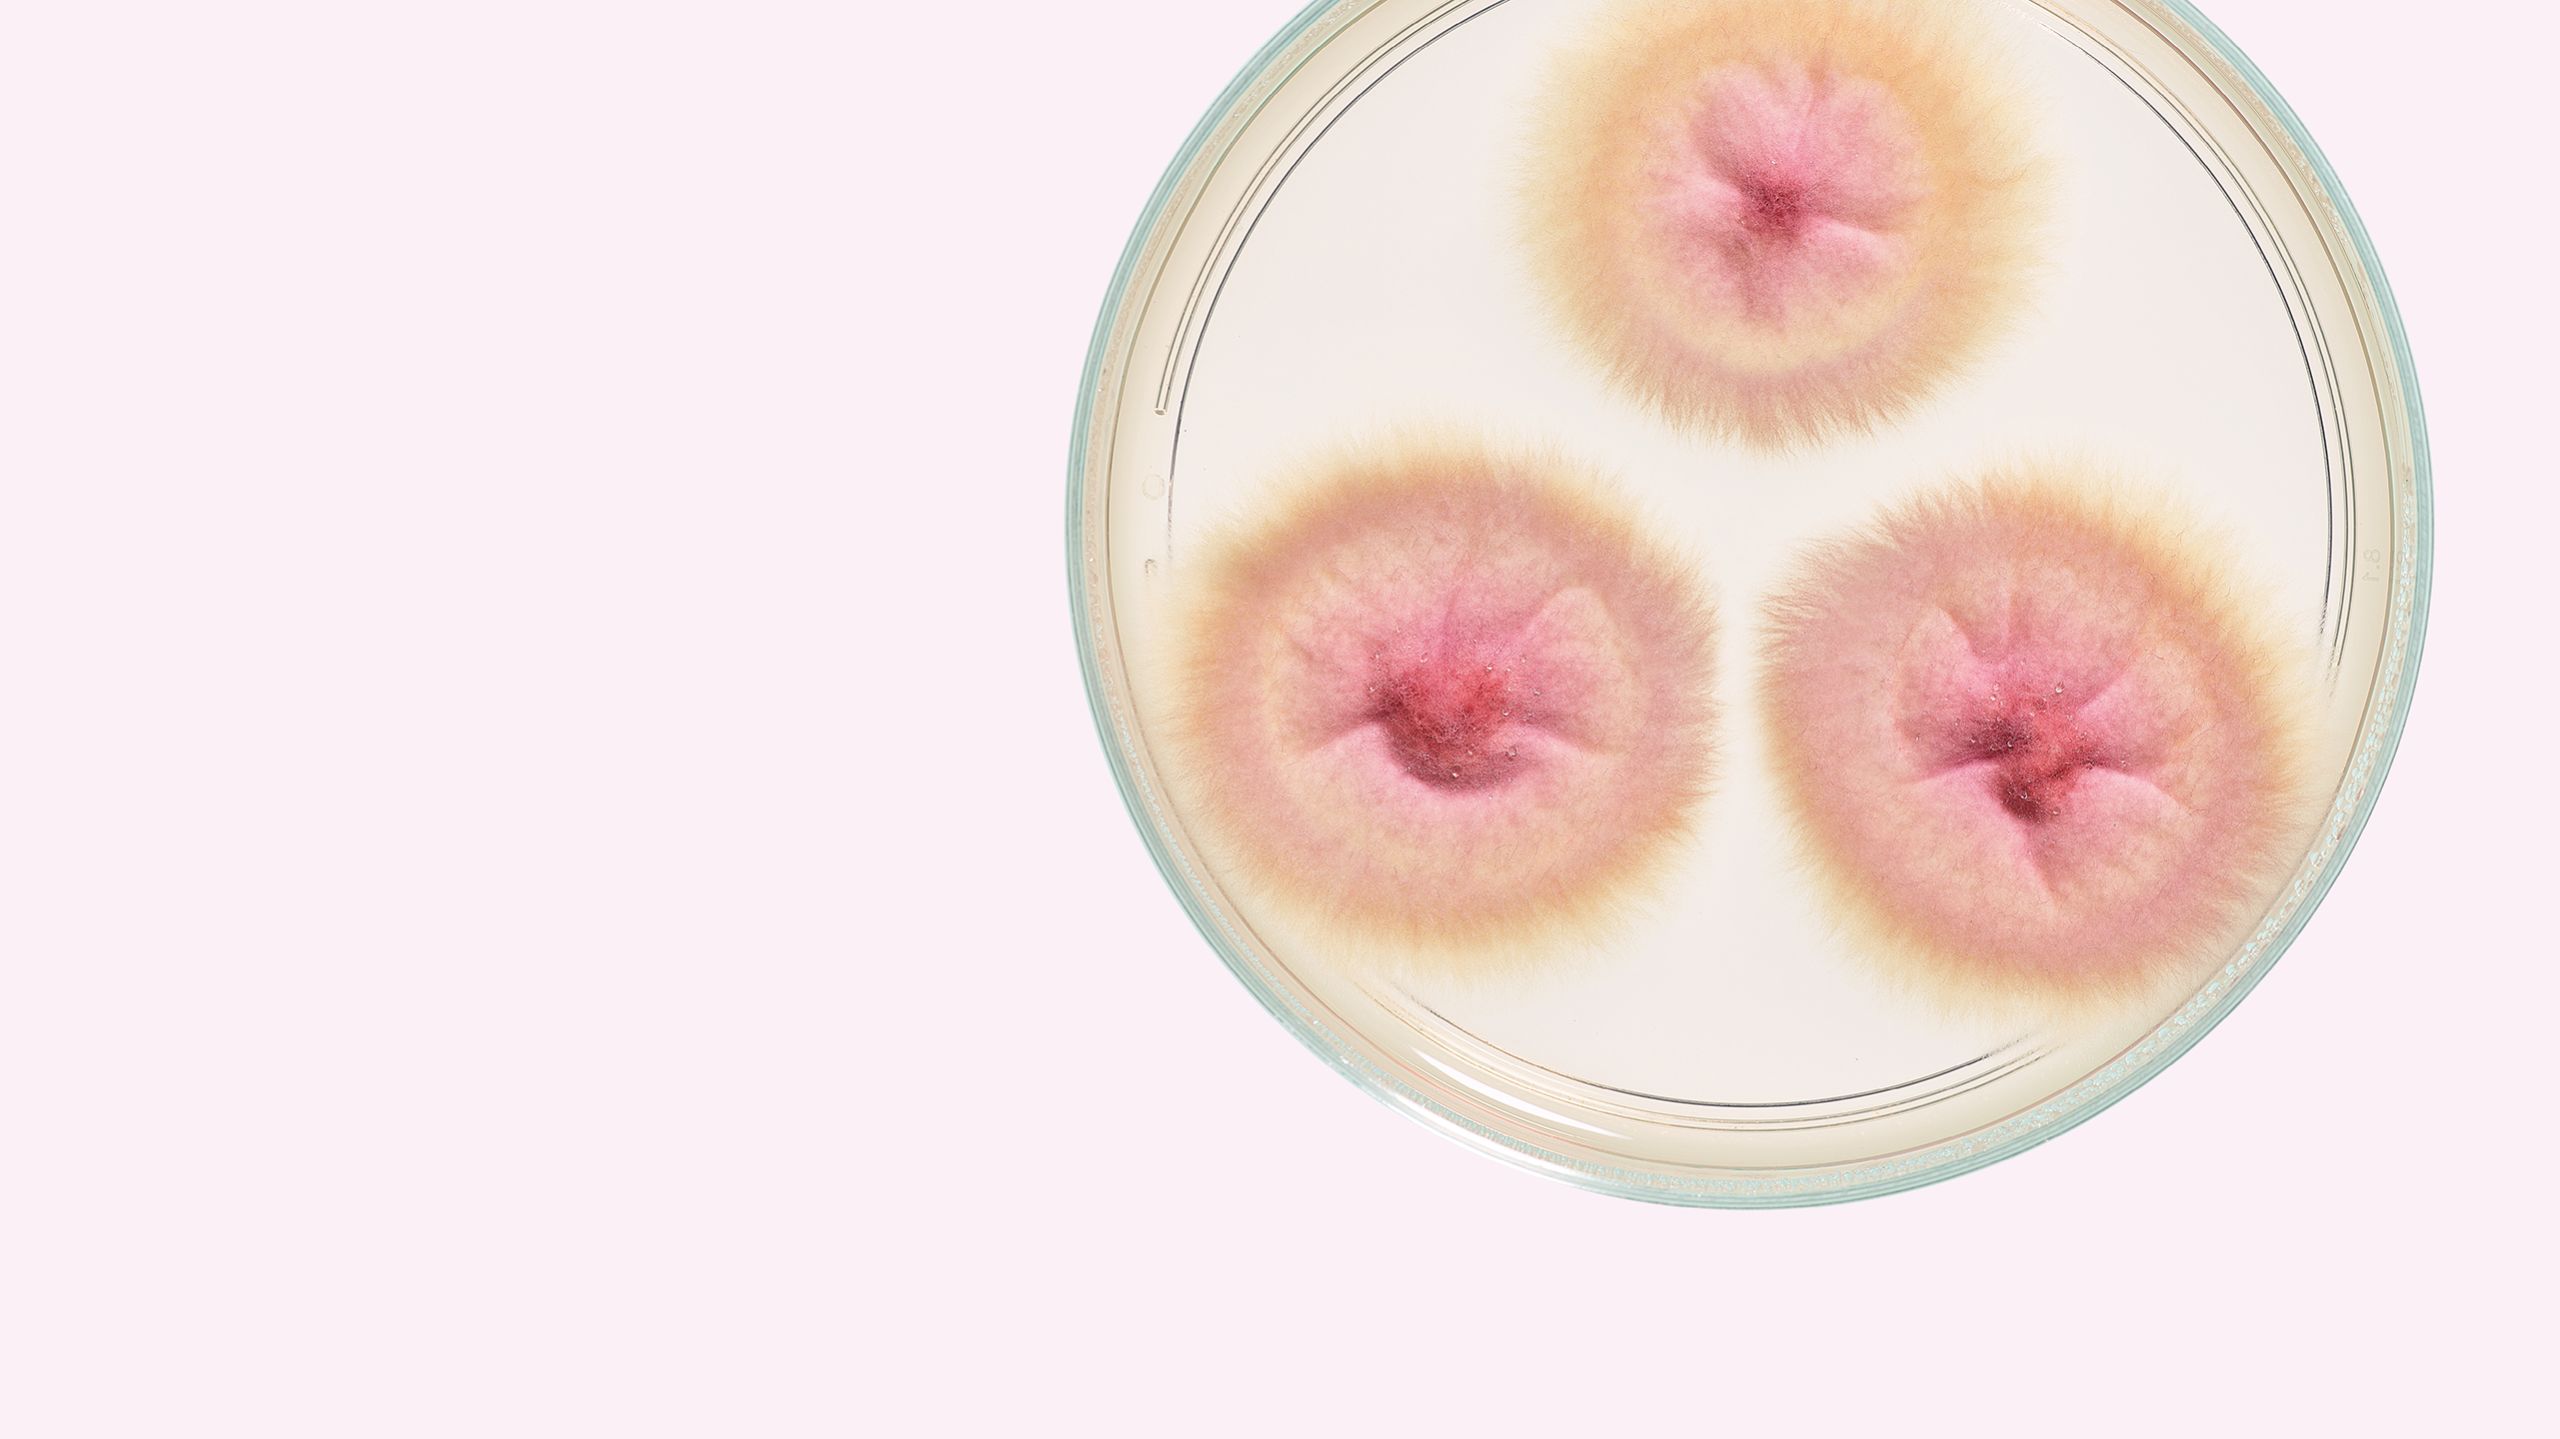
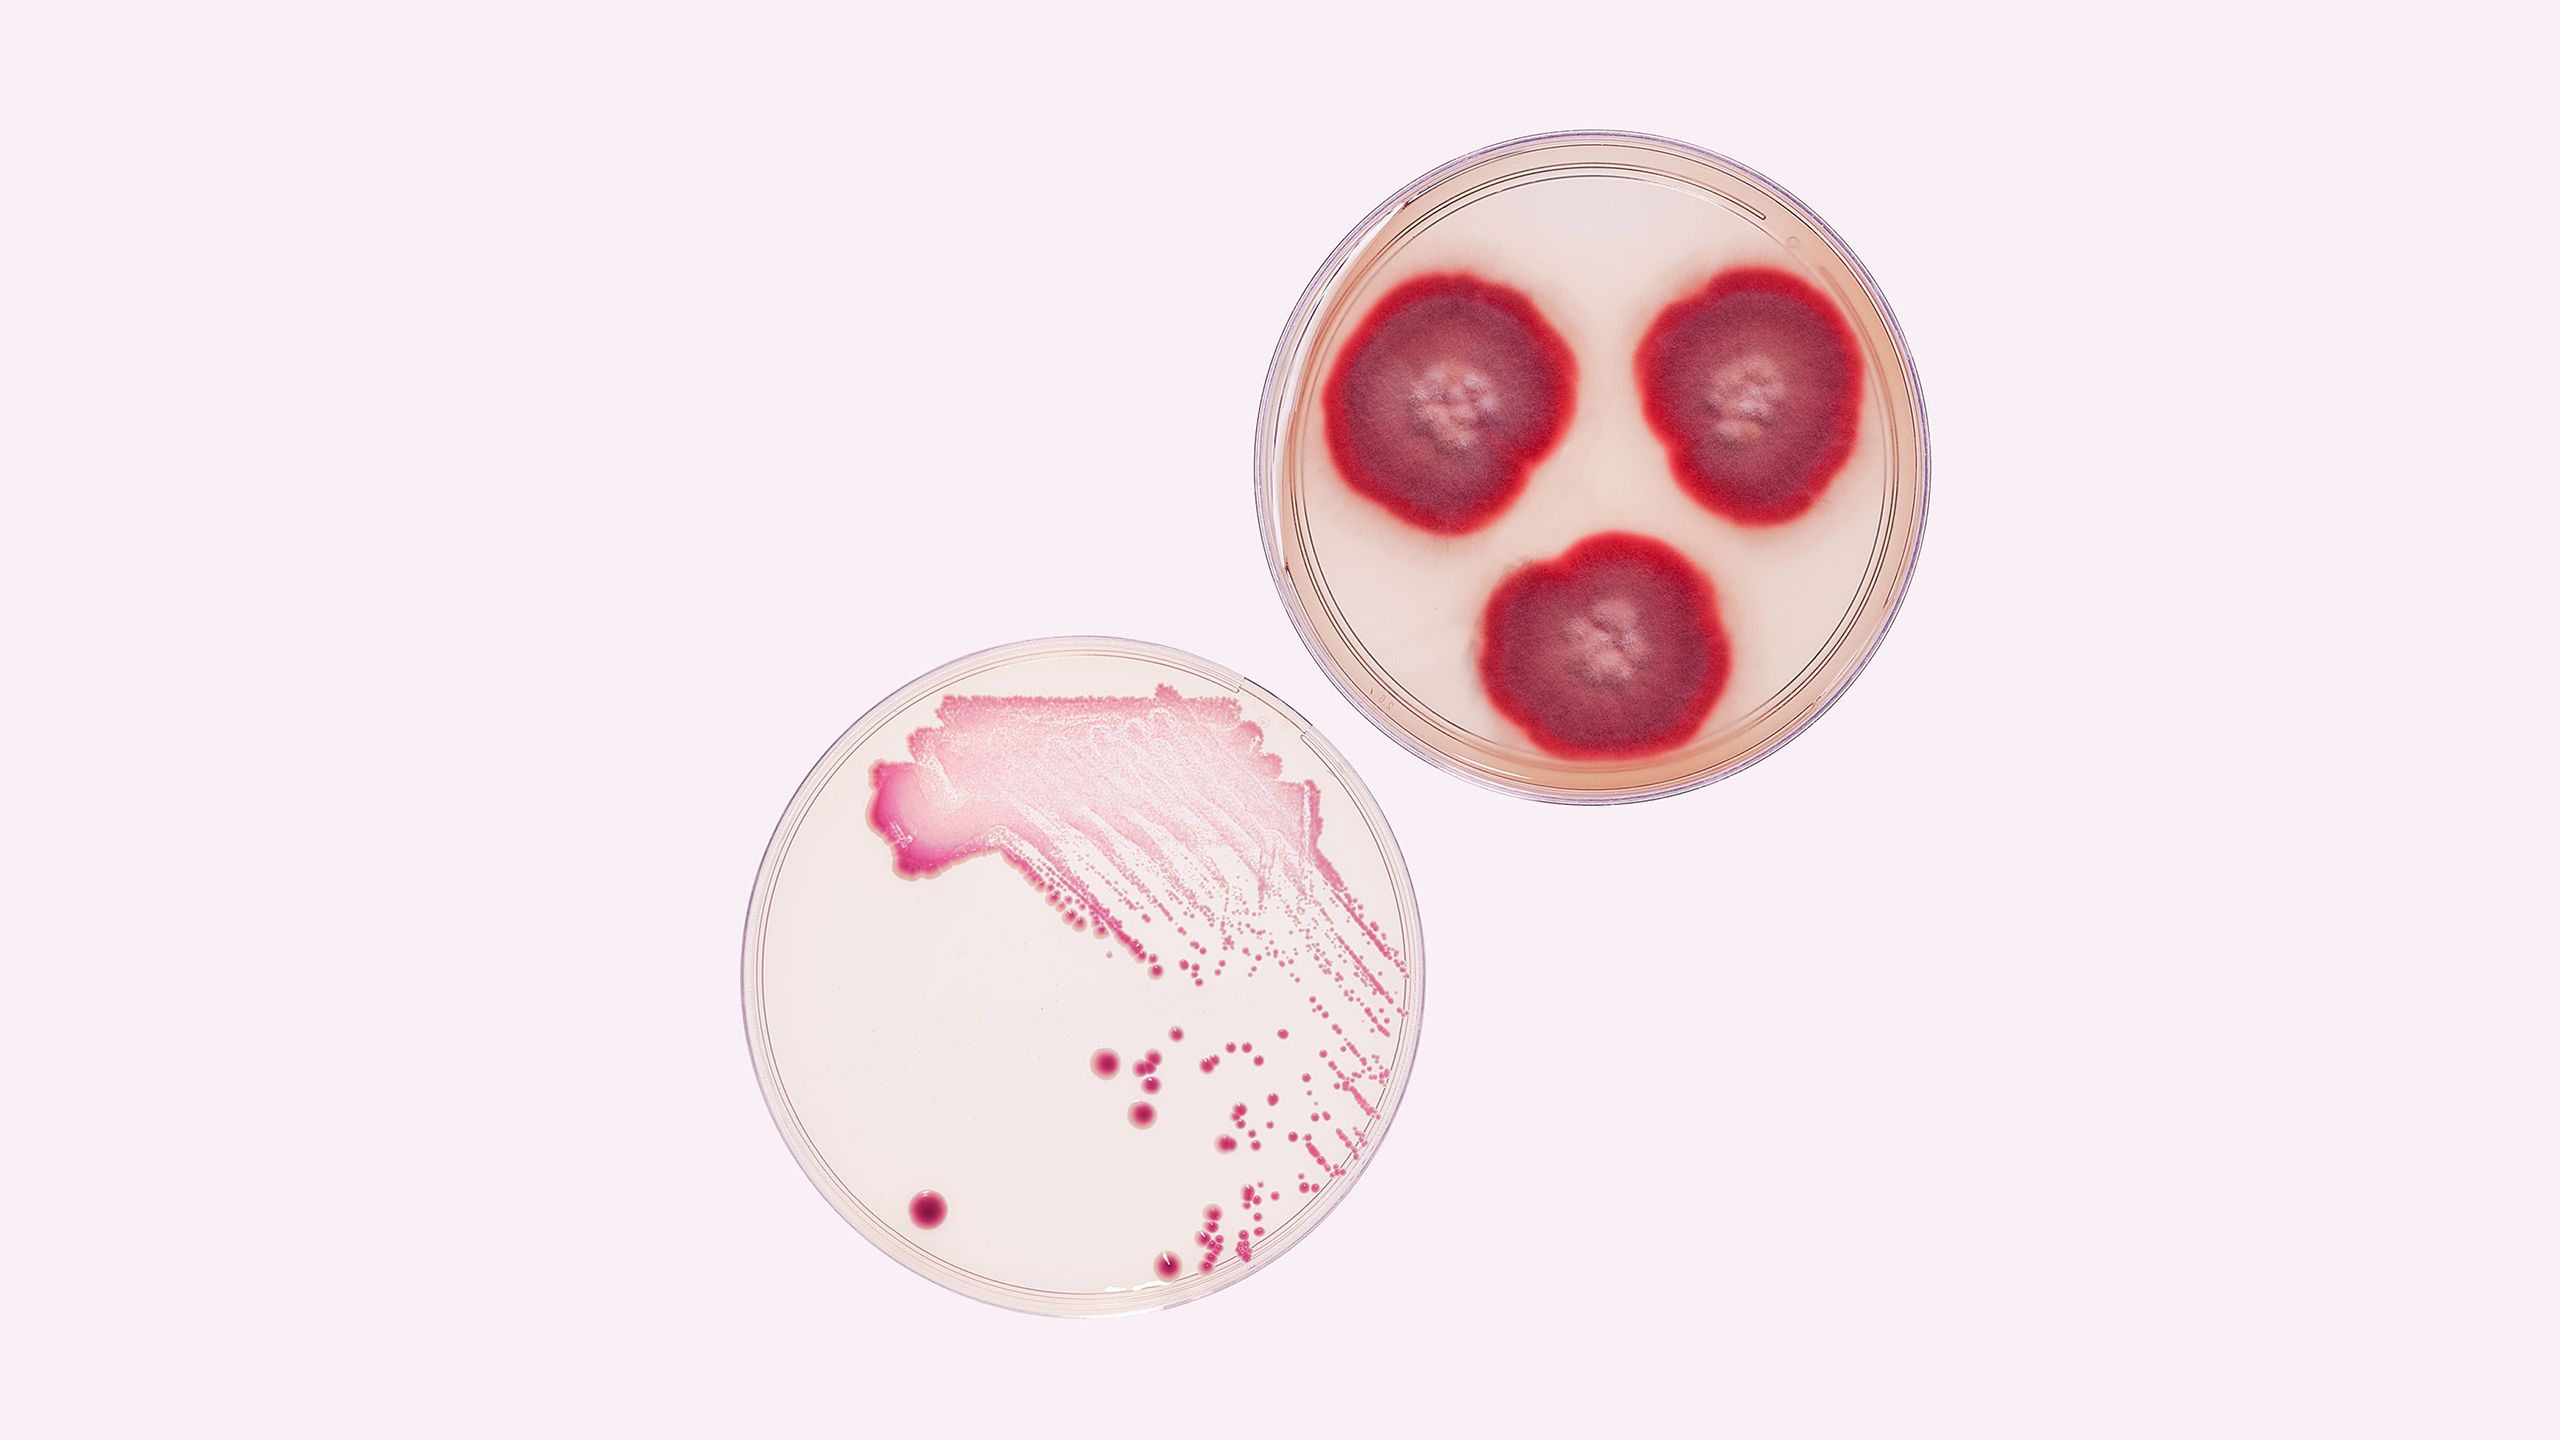
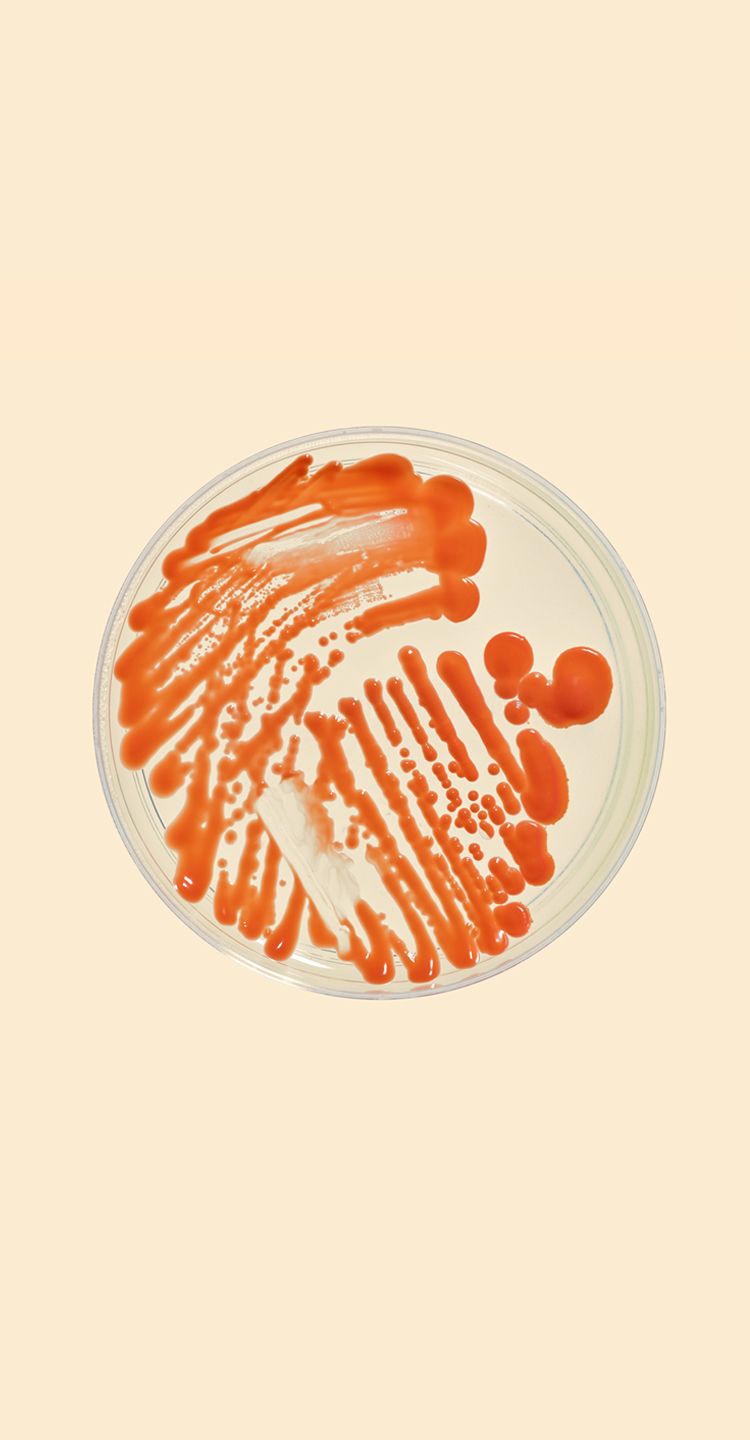

Antifungal resistance
Fungi are evolving – thankfully, Imperial researchers are leading the fight to protect us all.
Far from your average fungus
According to Dr Johanna Rhodes, one of the most dangerous fungi on the planet is like a comic-book supervillain.
“It seems able to withstand everything,” says Rhodes. “It’s almost as if it was designed: it’s too good at surviving, too good at evolving – it’s like nothing we’ve ever seen in a fungal pathogen.”
Clearly, Candida auris is far from your average fungus. Named because it was discovered in the ear of a hospital patient in Japan in 2009, C. auris has since emerged on every continent except Antarctica, infecting hundreds of vulnerable patients in dozens of healthcare facilities across more than 30 countries.
It seems able to withstand everything. It’s too good at surviving, too good at evolving – it’s like nothing we’ve ever seen in a fungal pathogen.
Without prompt diagnosis, mortality rates are high. Even more worrying for researchers like Rhodes is how hard it is to kill – and how little we know about it.
“It popped up simultaneously on three continents, with three different mechanisms of resistance to the same drug, causing all these infections in the space of a couple of years – that’s unheard of,” she explains .
Rhodes began working on C. auris in 2015, when the Royal Brompton Hospital asked her to help control a major outbreak among cardiothoracic patients in intensive care.
Using the latest genome-sequencing techniques and old-fashioned sleuthing (Rhodes’ parents were both detectives in the Staffordshire Police) she, together with colleagues from Imperial and the Royal Brompton, traced the source of infection to a contaminated ear thermometer. Impervious to traditional disinfectants, the fungus had spread silently between patients as their temperatures were taken.
Trichophyton rubrum (top right) and Candida auris (bottom left).
Trichophyton rubrum (top right) and Candida auris (bottom left).
Fungal infections are common throughout much of the natural world and, in humans, they occur when an invading fungus takes over an area of the body and is too much for the immune system to handle.
Around 300 fungi are known to be pathogenic to humans – capable of causing disease – but antifungal measures try to control their impact.
However, estimates suggest fungal diseases kill more than one million people every year – more than breast cancer or malaria.
And, worryingly, C. auris is just one of an increasing number of emerging pathogenic fungi that are becoming resistant to our limited arsenal of antifungal agents.
But it’s work on another fungus – Aspergillus fumigatus – by Imperial researchers that is truly revealing how fungi are evolving into such formidable foes.
The big difference between C. auris and the drug-resistant A. fumigatus is that we know more about the latter.
With a library of 600 isolates, Imperial has the world’s largest collection of genome-sequenced A. fumigatus, a fungus found in soils and decaying vegetation that infects humans when our defences are down.
But that knowledge makes its growth no less alarming.
Rhodotorula glutinis (top right) and Aspergillus fumigatus (bottom left).
Rhodotorula glutinis (top right) and Aspergillus fumigatus (bottom left).
An extraordinary organism
“It’s one of the most numerous organisms on the planet; it’s in almost every breath you take,” explains evolutionary ecologist Professor Matthew Fisher. “It’s an extraordinary organism.
"It thrives at high temperatures and secretes chemicals that can rot proteins, which allow it to grow in this nutrient-rich soup of the human being.
"But because we’ve lived with A. fumigatus for millions of years, a whole arm of our immune system is devoted to killing it. Without that, A. fumigatus would rot us down in a flash.”
While healthy people have nothing to fear, the trouble comes for those with cystic fibrosis, COPD and other chronic lung conditions, and people whose immune systems have been compromised by cancer treatment or organ transplants.
Because we’ve lived with A. fumigatus for millions of years, a whole arm of our immune system is devoted to killing it. Without that, it would rot us down in a flash.
Among these groups, the fungus causes aspergillosis, a potentially fatal infection that affects millions of people worldwide. Antifungal drugs worked to keep things in check – until those drugs started to fail.
In the mid-1990s, doctors in the Netherlands noticed rising death rates among patients with aspergillosis. A. fumigatus had developed resistance to previously effective triazole drugs.
Worst of all, the failures occurred in patients who had never taken the drugs, meaning the resistance must have arisen in the environment, and researchers urgently needed to find out how.
We cannot understand biological patterns without understanding their evolutionary underpinning – it’s like driving without a map.
“That’s where we came in,” says Fisher. “We started looking at patterns and processes underlying the evolution of azole resistance through the lens of genomic epidemiology.”
If Fisher’s lab has a strapline, it’s from US biologist Theodosius Dobzhansky who wrote: “Nothing in biology makes sense except in the light of evolution.”
According to Fisher: “We cannot understand biological patterns without understanding their evolutionary underpinning – it’s like driving without a map, you’d be lost.
"Sequencing the fungi’s genome from across the planet lets us see the underlying patterns and make sense of what we are seeing,” he says.
The genomic evidence is revealing that industrial-scale use of azole fungicides in agriculture and horticulture has driven A. fumigatus to evolve resistance to azoles – the same class of chemicals doctors rely on to treat human fungal infections – and this resistance is spreading around the world on wind-blown fungal spores and the horticultural trade.
“Dutch flower bulbs, for example, contain up to ten times more azole than a heavily sprayed field, and the Netherlands exports five billion bulbs a year around the world,” says Fisher.
“That’s the smoking gun that encouraged us to look for resistance closer to home.”
In 2018, Dr Thomas Sewell of the School of Public Health and MSc student Yuyi Zhang tested 200 soils across southern England – from Cambridgeshire farmland and the New Forest to Hampstead Heath and Kensal Green Cemetery – for azole-resistant A. fumigatus.
Finding it was not a problem, but where they found it was surprising and worrying.
“In places where we expected to find resistance – the agricultural fields – we found hardly any A. fumigatus and no resistant strains.
But flower beds in London and Bath, including flower beds outside two large London hospitals, were hotbeds of azole-resistant strains,” says Sewell.
“It shows that urban environments are an important part of the epidemiology of azole-resistant A. fumigatus, and bringing contaminated soils into cities through the horticultural trade could increase the spread of resistance.”
Clockwise from top: Aspergillus niger, Aspergillus terreus, and Aspergillus nidulans.
Clockwise from top: Aspergillus niger, Aspergillus terreus, and Aspergillus nidulans.
Chinks in the defence
With the genie long gone from the bottle, what can we do to mitigate the problem? According to Dr Nina Jiayue Zhu, a modeller using a whole-systems approach to antimicrobial resistance, everyone has a role to play.
“We can’t stop fungi evolving, but we can try to change human behaviour,” she says. “We know that inappropriate use of antifungal drugs in healthcare and over-the-counter creams is a key driver of resistance, so we need better policies and much more awareness of the issue.”
As a medical mycologist and infectious diseases physician, Dr Darius Armstrong-James (PhD Investigative Science 2005) helps treat patients with severe fungal diseases every day, but admits that the fungal diseases have been “underfunded, underappreciated and generally neglected” for too long.
We know that inappropriate use of antifungal drugs in healthcare and over-the-counter creams is a key driver of resistance.
And, as a researcher, Armstrong-James is trying to get to the bottom of why patients with weakened immune systems or chronic lung conditions suffer so many severe fungal infections.
“The big issue is that our existing treatments don’t work very well,” he explains. A chronic fungal chest infection needs three months’ treatment, and many patients need lifelong drugs, which is fuelling resistance. And designing new drugs is challenging because, biologically, fungal cells are so similar to those of animals.
“There aren’t many drug targets in fungi that don’t have a very similar target in humans, so they often have toxic side-effects.”
Today, there are 11 new drugs in development, from new classes of chemical and repurposed drugs, to compounds that have been reformulated so that they can be delivered to the site of infection without causing unwanted side-effects.
One such treatment is an inhalable drug developed by the Imperial startup Pulmocide, which is currently in trials at the Royal Brompton Hospital.
It's why Imperial’s work on A. fumigatus offers huge hope. “We have groups like the Fisher lab focused on the fungi – mapping why outbreaks occur and which isolates are pathogenic in humans – and researchers like me focused on the human host, understanding why certain individuals get fungal diseases,” he says.
“We’re starting to close the circle, because it’s only by getting a holistic view of these diseases that can we hope to mitigate them.”
Studying fungi
In his diagnostic mycology laboratory, Dr Ali Reza Abdolrasouli studies medically important fungi recovered from human clinical specimens.
While yeast cultures are often streaked on agar plates, filamentous fungi are inoculated into three spots per plate.
Then, the fungal cultures are examined at different times depending on the growth rate of each organism advanced technologies including mass spectrometry and genome sequencing are used to assist identification of fungal pathogens.
Trichophyton rubrum
Source: Human nail infection.
Growth conditions: Potato dextrose agar at 28°C for three weeks.
Cause: Common cause of tinea pedis (athlete's foot) worldwide, infecting both nail and skin.
Candida auris
Source: Human skin.
Growth conditions: Candida Chromogenic agar at 37°C for three days.
Cause: Multi-drug-resistant yeast emerging as a cause of healthcare-associated infections.
Aspergillus niger
Source: Human ear infection.
Growth conditions: Potato dextrose agar at 28°C for one week.
Cause: Most common cause of otomycosis (fungal ear infection) in immunocompetent individuals.
Aspergillus terreus
Source: Human respiratory infection.
Growth conditions: Sabouraud dextrose agar at 28°C for one week.
Cause: Invasive aspergillosis in immunocompromised patients. Intrinsic resistance to amphotericin B is of clinical concern.
Aspergillus nidulans
Source: Human soft tissue infection.
Growth conditions: Sabouraud dextrose agar at 28°C for two weeks.
Cause: Pale grain mycetoma and invasive aspergillosis in patients with chronic granulomatous disease.
Rhodotorula glutinis
Source: Human skin.
Growth conditions: Sabouraud dextrose agar at 28°C for one week.
Cause: This environmental yeast is commonly recovered from the human skin and nails of healthy individuals and rarely causes invasive infections in immunocompromised patients.
Aspergillus fumigatus
Source: Human respiratory infection.
Growth conditions: Sabouraud dextrose agar at 28°C for one week.
Cause: Predominant cause of aspergillosis in human and animals. Aspergillosis is a life-threatening infection in immunosupressed patients.
Trichophyton rubrum
Trichophyton rubrum
Candida auris
Candida auris
Aspergillus niger
Aspergillus niger
Aspergillus terreus
Aspergillus terreus
Aspergillus nidulans
Aspergillus nidulans
Rhodotorula glutinis
Rhodotorula glutinis
Aspergillus fumigatus
Aspergillus fumigatus
Imperial is the magazine for the Imperial community. It delivers expert comment, insight and context from – and on – the College’s engineers, mathematicians, scientists, medics, coders and leaders, as well as stories about student life and alumni experiences.
This story was published originally in Imperial 47/Winter 2019-20.